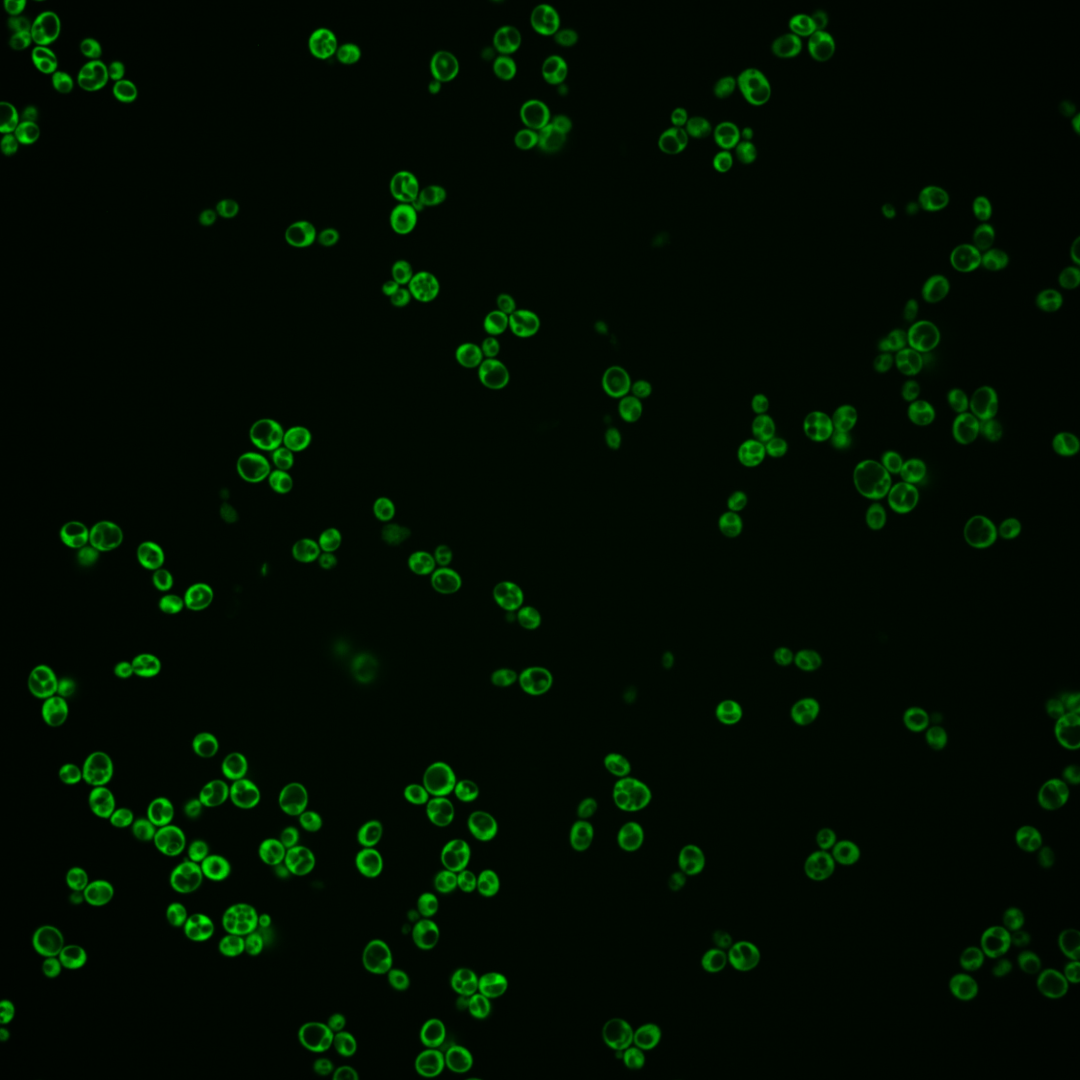
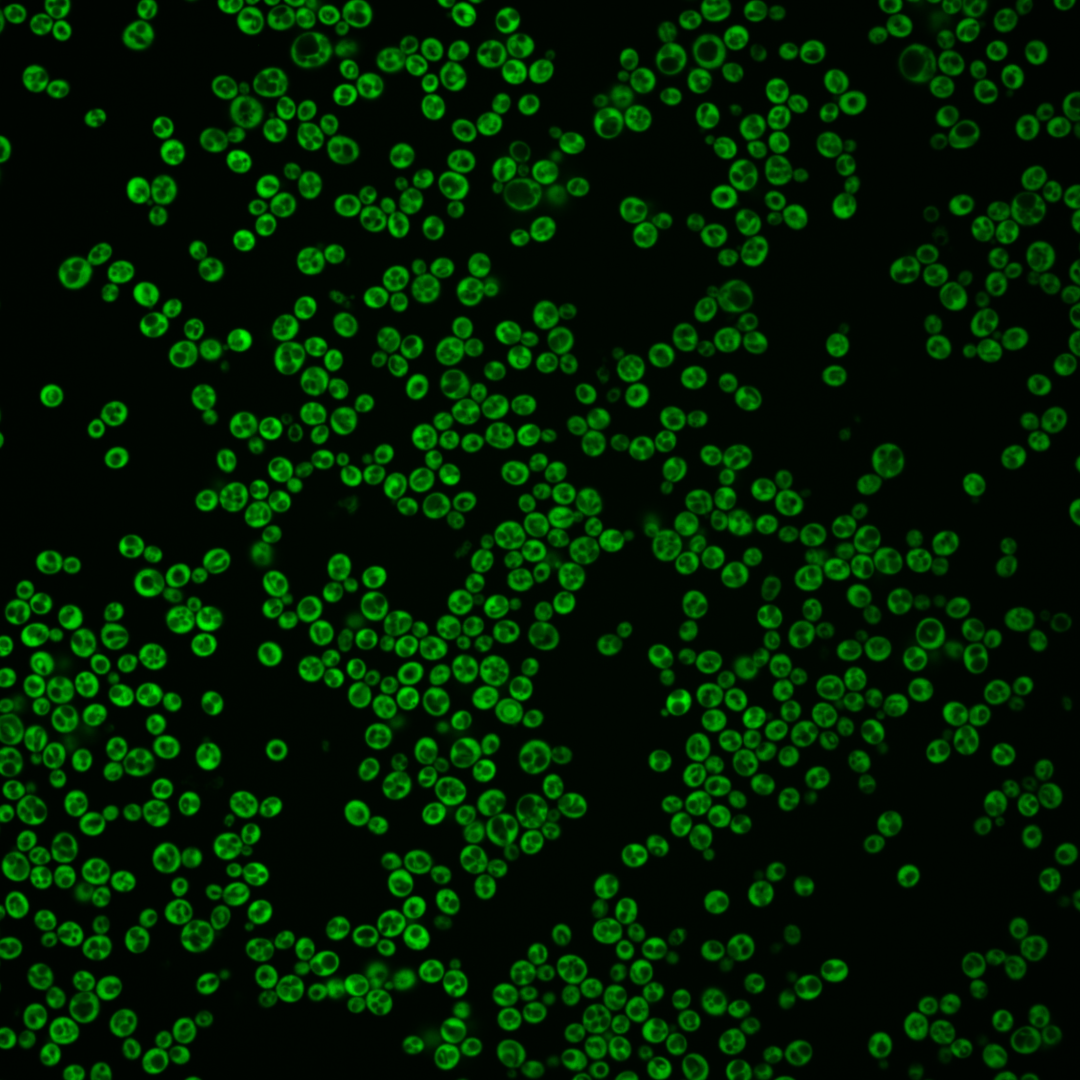
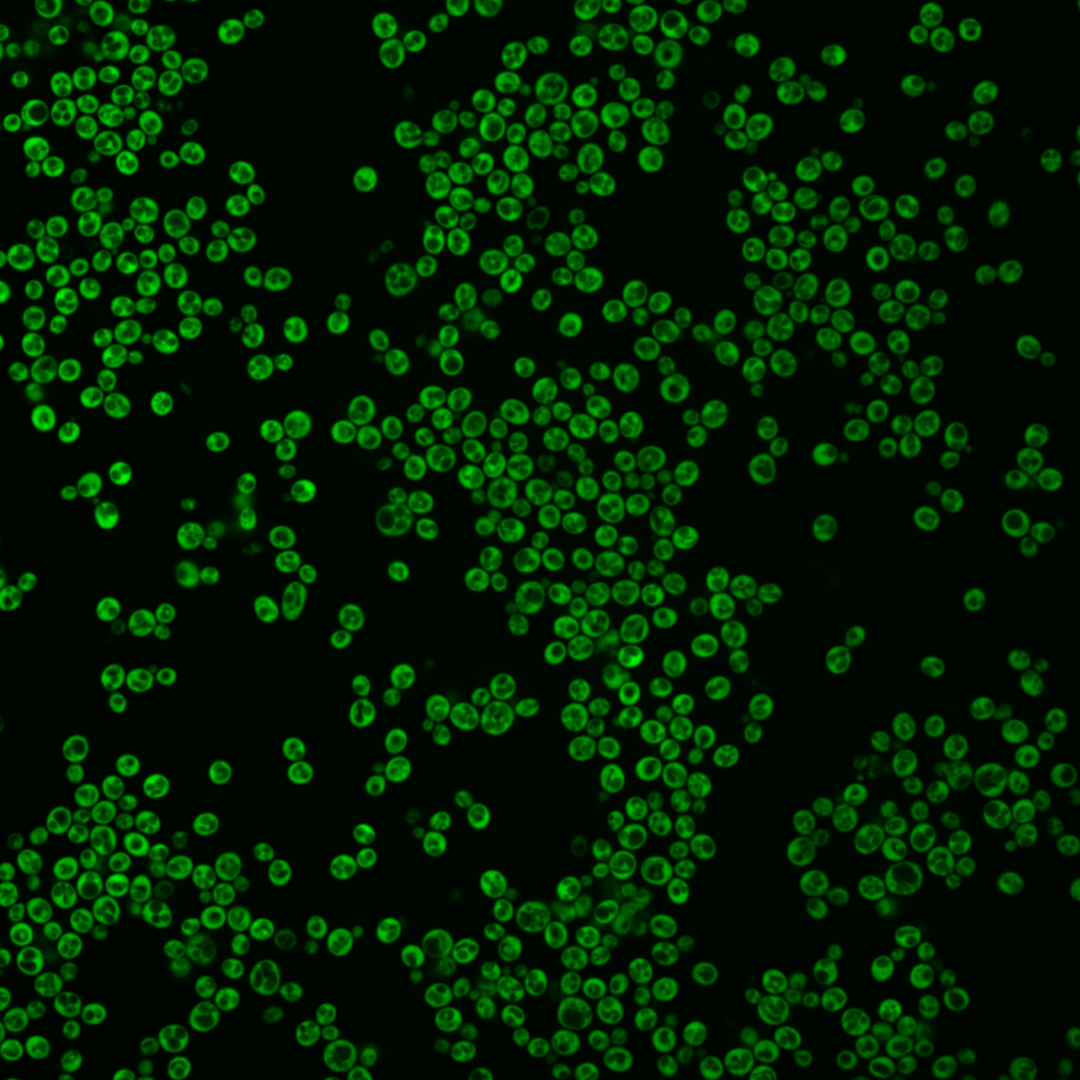
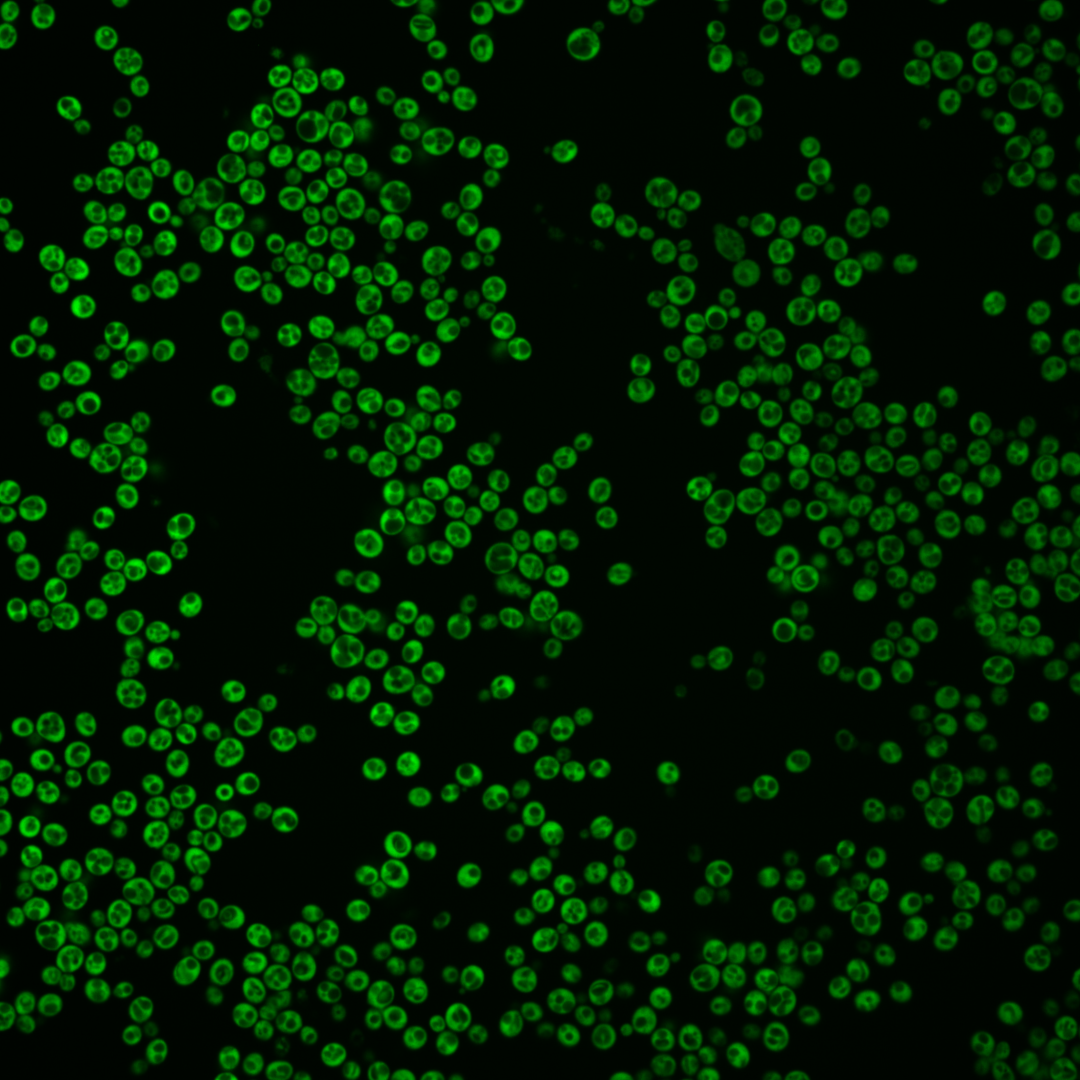
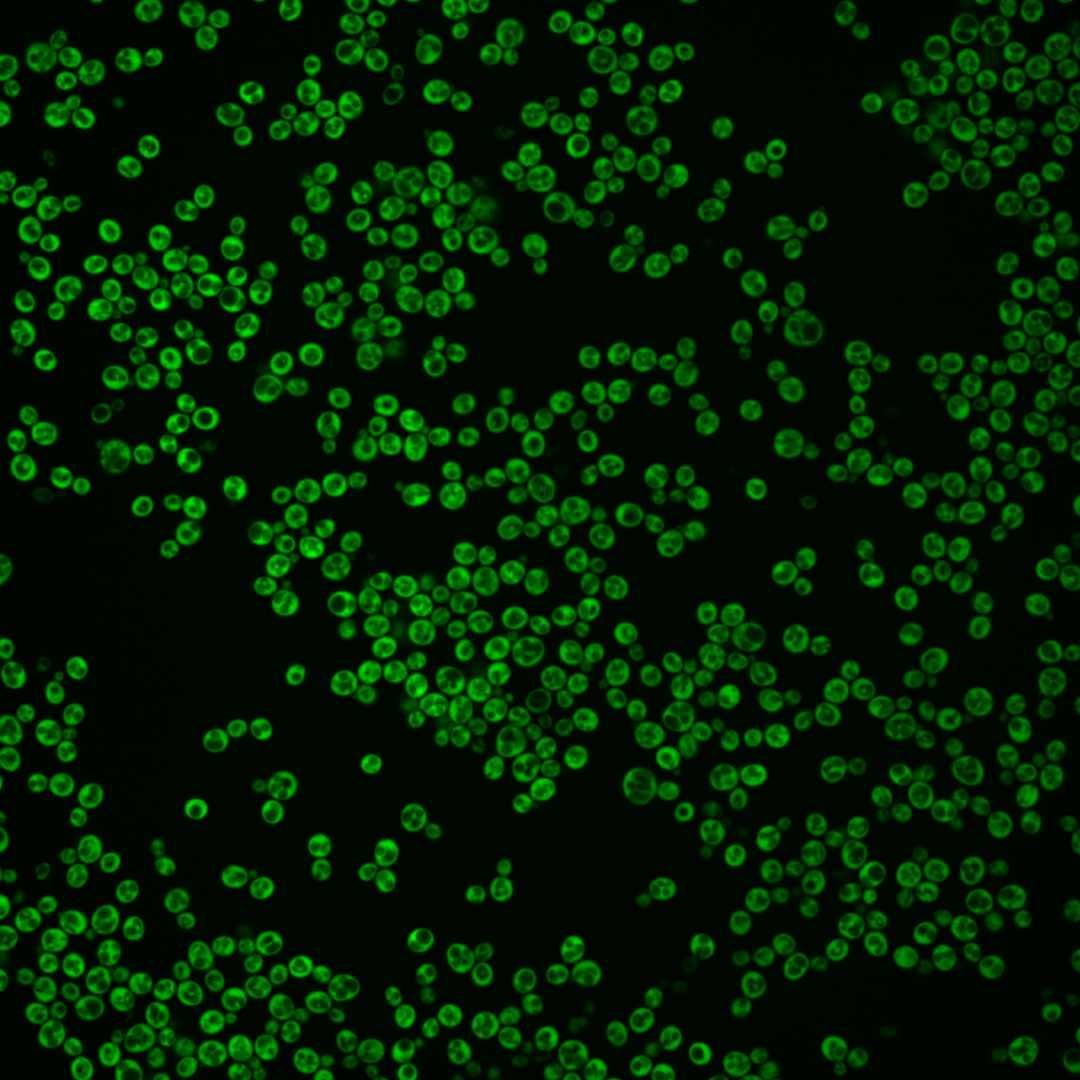

| Standard name | |
|---|---|
| Human Ortholog | |
| Description | Protein component of the small (40S) ribosomal subunit; homologous to mammalian ribosomal protein S30, no bacterial homolog; RPS30A has a paralog, RPS30B, that arose from the whole genome duplication |
Micrographs




















































































Sub-cellular Localization
Yeast GFP Assignment
Protein Abundance
Localization Change
External localization resources
| ensLOC | DeepLoc | |||||||||||||||||||||||
|---|---|---|---|---|---|---|---|---|---|---|---|---|---|---|---|---|---|---|---|---|---|---|---|---|
| Localization | WT1 | WT2 | WT3 | RAP60 | RAP140 | RAP220 | RAP300 | RAP380 | RAP460 | RAP540 | RAP620 | RAP700 | HU80 | HU120 | HU160 | rpd3Δ_1 | rpd3Δ_2 | rpd3Δ_3 | WT1 | WT2 | WT3 | AF100 | AF140 | AF180 |
| Cortical Patches | – | 0 | 0 | 0 | 1 | 2 | 12 | 16 | 8 | 17 | 14 | 31 | 0 | 0 | 0 | 1 | 0 | 0 | 0 | 0 | 0 | 0 | 0 | 1 |
| Bud | – | 1 | 0 | 1 | 1 | 0 | 0 | 0 | 0 | 2 | 2 | 1 | 1 | 1 | 2 | 0 | 0 | 1 | 0 | 0 | 0 | 0 | 3 | 6 |
| Bud Neck | – | 0 | 0 | 0 | 0 | 0 | 0 | 0 | 0 | 0 | 0 | 0 | 0 | 0 | 0 | 0 | 0 | 0 | 0 | 0 | 0 | 0 | 0 | 0 |
| Bud Site | – | 0 | 0 | 0 | 0 | 0 | 0 | 0 | 0 | 0 | 0 | 0 | 0 | 0 | 0 | 0 | 0 | 0 | – | – | – | – | – | – |
| Cell Periphery | – | 0 | 0 | 1 | 5 | 1 | 28 | 18 | 5 | 16 | 24 | 35 | 2 | 5 | 4 | 3 | 4 | 6 | 0 | 0 | 0 | 0 | 0 | 0 |
| Cytoplasm | – | 103 | 47 | 130 | 201 | 97 | 223 | 273 | 92 | 139 | 163 | 201 | 191 | 405 | 447 | 363 | 357 | 417 | 22 | 114 | 67 | 275 | 405 | 437 |
| Endoplasmic Reticulum | – | 2 | 1 | 1 | 7 | 7 | 51 | 63 | 14 | 39 | 50 | 55 | 5 | 4 | 7 | 13 | 16 | 14 | 1 | 1 | 1 | 9 | 25 | 18 |
| Endosome | – | 0 | 0 | 0 | 0 | 0 | 0 | 0 | 0 | 0 | 0 | 0 | 0 | 0 | 0 | 0 | 0 | 1 | 0 | 0 | 0 | 0 | 0 | 0 |
| Golgi | – | 0 | 1 | 0 | 1 | 1 | 13 | 15 | 5 | 11 | 18 | 23 | 0 | 0 | 0 | 2 | 2 | 1 | 0 | 0 | 0 | 1 | 0 | 0 |
| Mitochondria | – | 0 | 0 | 0 | 0 | 5 | 0 | 6 | 15 | 4 | 34 | 33 | 0 | 0 | 0 | 1 | 1 | 0 | 0 | 0 | 0 | 2 | 2 | 0 |
| Nucleus | – | 0 | 0 | 0 | 0 | 0 | 0 | 2 | 1 | 1 | 3 | 0 | 0 | 0 | 0 | 0 | 0 | 0 | 2 | 0 | 0 | 1 | 1 | 1 |
| Nuclear Periphery | – | 0 | 0 | 0 | 0 | 0 | 0 | 0 | 0 | 0 | 0 | 0 | 0 | 0 | 0 | 0 | 0 | 0 | 0 | 0 | 0 | 0 | 0 | 0 |
| Nucleolus | – | 0 | 0 | 0 | 0 | 0 | 0 | 0 | 0 | 0 | 0 | 0 | 0 | 0 | 0 | 0 | 0 | 0 | 0 | 0 | 0 | 0 | 0 | 0 |
| Peroxisomes | – | 0 | 0 | 0 | 0 | 0 | 0 | 0 | 0 | 0 | 0 | 1 | 0 | 0 | 0 | 0 | 0 | 0 | 0 | 0 | 0 | 0 | 0 | 0 |
| SpindlePole | – | 0 | 0 | 0 | 0 | 0 | 0 | 0 | 0 | 0 | 0 | 0 | 0 | 0 | 0 | 0 | 0 | 0 | 0 | 0 | 0 | 0 | 0 | 0 |
| Vac/Vac Membrane | – | 0 | 0 | 0 | 1 | 4 | 2 | 5 | 4 | 6 | 2 | 11 | 0 | 2 | 0 | 3 | 8 | 1 | 0 | 2 | 0 | 6 | 5 | 4 |
| Unique Cell Count | 106 | 48 | 133 | 212 | 114 | 299 | 366 | 124 | 211 | 262 | 320 | 195 | 411 | 453 | 372 | 370 | 425 | 27 | 120 | 71 | 300 | 451 | 477 | |
| Labelled Cell Count | 106 | 49 | 133 | 217 | 117 | 329 | 398 | 144 | 235 | 310 | 391 | 199 | 417 | 460 | 386 | 388 | 441 | 27 | 120 | 71 | 300 | 451 | 477 | |
Yeast GFP Assignment
Protein Abundance
| Screen | WT1 | WT2 | WT3 | RAP60 | RAP140 | RAP220 | RAP300 | RAP380 | RAP460 | RAP540 | RAP620 | RAP700 | HU80 | HU120 | HU160 | rpd3Δ_1 | rpd3Δ_2 | rpd3Δ_3 | AF100 | AF140 | AF180 |
|---|---|---|---|---|---|---|---|---|---|---|---|---|---|---|---|---|---|---|---|---|---|
| Mean Cell GFP Intensity (1e-4) | 10.4 | 92.8 | 76.2 | 79.0 | 60.3 | 31.5 | 36.5 | 32.0 | 23.9 | 22.7 | 20.7 | 19.0 | 84.8 | 88.3 | 85.9 | 85.3 | 82.9 | 93.8 | 75.2 | 81.7 | 85.1 |
| Std Deviation (1e-4) | 1.6 | 19.7 | 19.7 | 21.1 | 14.9 | 12.2 | 9.1 | 7.9 | 6.7 | 6.7 | 6.6 | 5.6 | 19.7 | 25.5 | 23.0 | 26.9 | 26.3 | 31.3 | 19.2 | 21.4 | 23.7 |
| Intensity Change (Log2) | – | – | – | 0.05 | -0.34 | -1.28 | -1.06 | -1.25 | -1.67 | -1.75 | -1.88 | -2.01 | 0.15 | 0.21 | 0.17 | 0.16 | 0.12 | 0.3 | -0.02 | 0.1 | 0.16 |
Localization Change
| Localization | RAP60 | RAP140 | RAP220 | RAP300 | RAP380 | RAP460 | RAP540 | RAP620 | RAP700 | HU80 | HU120 | HU160 | rpd3Δ_1 | rpd3Δ_2 | rpd3Δ_3 |
|---|---|---|---|---|---|---|---|---|---|---|---|---|---|---|---|
| Cortical Patches | 0 | 0 | 0 | 0 | 0 | 0 | 0 | 0 | 0 | 0 | 0 | 0 | 0 | 0 | 0 |
| Bud | 0 | 0 | 0 | 0 | 0 | 0 | 0 | 0 | 0 | 0 | 0 | 0 | 0 | 0 | 0 |
| Bud Neck | 0 | 0 | 0 | 0 | 0 | 0 | 0 | 0 | 0 | 0 | 0 | 0 | 0 | 0 | 0 |
| Bud Site | 0 | 0 | 0 | 0 | 0 | 0 | 0 | 0 | 0 | 0 | 0 | 0 | 0 | 0 | 0 |
| Cell Periphery | 0 | 0 | 0 | 0 | 0 | 0 | 0 | 0 | 0 | 0 | 0 | 0 | 0 | 0 | 0 |
| Cytoplasm | -0.1 | -0.9 | -2.4 | -3.6 | -3.6 | -3.5 | -4.5 | -4.9 | -4.8 | 0 | 0.3 | 0.4 | -0.1 | -0.5 | 0.1 |
| Endoplasmic Reticulum | 0 | 0 | 0 | 2.7 | 2.7 | 0 | 2.8 | 2.9 | 2.7 | 0 | 0 | 0 | 0 | 0 | 0 |
| Endosome | 0 | 0 | 0 | 0 | 0 | 0 | 0 | 0 | 0 | 0 | 0 | 0 | 0 | 0 | 0 |
| Golgi | 0 | 0 | 0 | 0 | 0 | 0 | 0 | 0 | 0 | 0 | 0 | 0 | 0 | 0 | 0 |
| Mitochondria | 0 | 0 | 0 | 0 | 0 | 0 | 0 | 2.6 | 0 | 0 | 0 | 0 | 0 | 0 | 0 |
| Nucleus | 0 | 0 | 0 | 0 | 0 | 0 | 0 | 0 | 0 | 0 | 0 | 0 | 0 | 0 | 0 |
| Nuclear Periphery | 0 | 0 | 0 | 0 | 0 | 0 | 0 | 0 | 0 | 0 | 0 | 0 | 0 | 0 | 0 |
| Nucleolus | 0 | 0 | 0 | 0 | 0 | 0 | 0 | 0 | 0 | 0 | 0 | 0 | 0 | 0 | 0 |
| Peroxisomes | 0 | 0 | 0 | 0 | 0 | 0 | 0 | 0 | 0 | 0 | 0 | 0 | 0 | 0 | 0 |
| SpindlePole | 0 | 0 | 0 | 0 | 0 | 0 | 0 | 0 | 0 | 0 | 0 | 0 | 0 | 0 | 0 |
| Vacuole | 0 | 0 | 0 | 0 | 0 | 0 | 0 | 0 | 0 | 0 | 0 | 0 | 0 | 0 | 0 |
External localization resources
Images






























Protein Concentration and Protein Localization Data
| R1 | R2 | R3 | ||||||||||||||||
|---|---|---|---|---|---|---|---|---|---|---|---|---|---|---|---|---|---|---|
| G1 Pre-START | G1 Post-START | S/G2 | Metaphase | Anaphase | Telophase | G1 Pre-START | G1 Post-START | S/G2 | Metaphase | Anaphase | Telophase | G1 Pre-START | G1 Post-START | S/G2 | Metaphase | Anaphase | Telophase | |
| Concentration | 75.0408 | 95.9111 | 86.3187 | 69.9531 | 55.0693 | 73.4708 | 83.4307 | 141.6651 | 125.4177 | 102.9329 | 87.4047 | 87.4918 | 95.5086 | 127.6902 | 116.2305 | 117.8093 | 84.0568 | 122.4045 |
| Actin | 0.0021 | 0.0006 | 0.0019 | 0.0258 | 0.0045 | 0.0069 | 0.0247 | 0.0009 | 0.0253 | 0.0113 | 0.0018 | 0.026 | 0.0084 | 0.0002 | 0.0113 | 0.0001 | 0.0076 | 0.0016 |
| Bud | 0.0059 | 0.0075 | 0.0064 | 0.0037 | 0.0048 | 0.0033 | 0.0043 | 0.001 | 0.0027 | 0.0112 | 0.0133 | 0.0102 | 0.0025 | 0.0008 | 0.0016 | 0.0012 | 0.002 | 0.0034 |
| Bud Neck | 0.0008 | 0.0004 | 0.0013 | 0.0014 | 0.0011 | 0.0019 | 0.0009 | 0.0007 | 0.001 | 0.0012 | 0.0023 | 0.0022 | 0.0023 | 0.0003 | 0.0005 | 0.0004 | 0.0021 | 0.0013 |
| Bud Periphery | 0.0098 | 0.005 | 0.0056 | 0.003 | 0.0118 | 0.0021 | 0.0084 | 0.0006 | 0.0049 | 0.0239 | 0.0127 | 0.0118 | 0.003 | 0.0003 | 0.0006 | 0.0003 | 0.0009 | 0.001 |
| Bud Site | 0.0021 | 0.0026 | 0.0026 | 0.0139 | 0.0023 | 0.0008 | 0.0035 | 0.001 | 0.0078 | 0.0115 | 0.0014 | 0.0014 | 0.0094 | 0.0005 | 0.0009 | 0.0001 | 0.0053 | 0.0003 |
| Cell Periphery | 0.0222 | 0.0087 | 0.0185 | 0.0119 | 0.0081 | 0.0025 | 0.0362 | 0.0249 | 0.0333 | 0.0117 | 0.0149 | 0.0129 | 0.026 | 0.0044 | 0.003 | 0.0007 | 0.0021 | 0.003 |
| Cytoplasm | 0.6137 | 0.9072 | 0.7457 | 0.5863 | 0.507 | 0.6344 | 0.4731 | 0.8434 | 0.6994 | 0.5893 | 0.5077 | 0.5265 | 0.635 | 0.9375 | 0.8477 | 0.7987 | 0.6649 | 0.7904 |
| Cytoplasmic Foci | 0.0437 | 0.0012 | 0.023 | 0.0104 | 0.0989 | 0.0135 | 0.0212 | 0.0007 | 0.0135 | 0.0361 | 0.0253 | 0.0494 | 0.0096 | 0.001 | 0.0038 | 0.0018 | 0.0233 | 0.0065 |
| Eisosomes | 0.0003 | 0 | 0.0002 | 0.0008 | 0.0005 | 0.0001 | 0.0004 | 0.0001 | 0.001 | 0.0001 | 0.0003 | 0.0008 | 0.0008 | 0 | 0.0002 | 0 | 0.0002 | 0 |
| Endoplasmic Reticulum | 0.0288 | 0.0035 | 0.0038 | 0.0032 | 0.0072 | 0.0195 | 0.0155 | 0.0023 | 0.0061 | 0.0023 | 0.0091 | 0.0108 | 0.0354 | 0.0024 | 0.0038 | 0.0155 | 0.0047 | 0.009 |
| Endosome | 0.0125 | 0.0018 | 0.0088 | 0.0342 | 0.0365 | 0.0732 | 0.043 | 0.0015 | 0.0169 | 0.0357 | 0.0665 | 0.0076 | 0.0128 | 0.0017 | 0.0127 | 0.0094 | 0.0375 | 0.0145 |
| Golgi | 0.0022 | 0.0002 | 0.001 | 0.0234 | 0.0055 | 0.024 | 0.0095 | 0.0003 | 0.0062 | 0.0076 | 0.0156 | 0.008 | 0.0033 | 0.0002 | 0.001 | 0.0001 | 0.0084 | 0.0033 |
| Lipid Particles | 0.0092 | 0.0002 | 0.0048 | 0.0028 | 0.0122 | 0.0019 | 0.0113 | 0.0009 | 0.0028 | 0.0156 | 0.0115 | 0.0294 | 0.0036 | 0.0001 | 0.0012 | 0.0001 | 0.0078 | 0.0011 |
| Mitochondria | 0.01 | 0.0003 | 0.007 | 0.0257 | 0.0625 | 0.0279 | 0.0223 | 0.0076 | 0.0074 | 0.0053 | 0.0626 | 0.0226 | 0.0091 | 0.0002 | 0.0031 | 0.0002 | 0.0057 | 0.0068 |
| None | 0.0161 | 0.0003 | 0.0065 | 0.0025 | 0.0374 | 0.0054 | 0.0116 | 0.0002 | 0.0053 | 0.0017 | 0.0169 | 0.017 | 0.0164 | 0.0001 | 0.0025 | 0.0002 | 0.0071 | 0.0009 |
| Nuclear Periphery | 0.0164 | 0.0013 | 0.0036 | 0.0039 | 0.0071 | 0.0231 | 0.0318 | 0.0043 | 0.0149 | 0.0038 | 0.0118 | 0.0234 | 0.0252 | 0.0013 | 0.0115 | 0.0052 | 0.0175 | 0.0046 |
| Nucleolus | 0.0125 | 0.0002 | 0.0076 | 0.001 | 0.0238 | 0.0086 | 0.0086 | 0.0003 | 0.0009 | 0.0012 | 0.0084 | 0.0158 | 0.0022 | 0.0001 | 0.0003 | 0.0001 | 0.0006 | 0.0006 |
| Nucleus | 0.0135 | 0.0015 | 0.0049 | 0.0046 | 0.0108 | 0.0434 | 0.021 | 0.0028 | 0.0077 | 0.0055 | 0.0087 | 0.0112 | 0.0089 | 0.0014 | 0.0042 | 0.0027 | 0.0128 | 0.0043 |
| Peroxisomes | 0.001 | 0 | 0.0009 | 0.0018 | 0.002 | 0.0006 | 0.0031 | 0.0001 | 0.0005 | 0.0028 | 0.0028 | 0.0032 | 0.0025 | 0 | 0.0004 | 0 | 0.0343 | 0.0002 |
| Punctate Nuclear | 0.0036 | 0 | 0.0006 | 0.0004 | 0.0114 | 0.0015 | 0.0121 | 0 | 0.0017 | 0.0027 | 0.0039 | 0.0047 | 0.0037 | 0 | 0.001 | 0 | 0.0055 | 0.0001 |
| Vacuole | 0.1461 | 0.0529 | 0.124 | 0.2043 | 0.1167 | 0.0641 | 0.1996 | 0.0997 | 0.1268 | 0.1899 | 0.1587 | 0.1641 | 0.1487 | 0.0426 | 0.0713 | 0.1248 | 0.123 | 0.1082 |
| Vacuole Periphery | 0.0274 | 0.0043 | 0.0213 | 0.0348 | 0.0281 | 0.0413 | 0.0379 | 0.0069 | 0.0139 | 0.0296 | 0.0438 | 0.041 | 0.0312 | 0.0052 | 0.0172 | 0.0384 | 0.0266 | 0.0389 |
Sequencing Data
| R1 | R2 | |||||||||
|---|---|---|---|---|---|---|---|---|---|---|
| G1 Post-START | S/G2 | Metaphase | Anaphase | Telophase | G1 Post-START | S/G2 | Metaphase | Anaphase | Telophase | |
| Gene Expression | 1744.1836 | 1669.6472 | 2150.0552 | 1837.5404 | 2421.609 | 1700.1401 | 1579.0962 | 1786.2392 | 1902.3203 | 1675.2417 |
| Translational Efficiency | 1.6977 | 1.7238 | 1.3173 | 1.8069 | 1.5524 | 1.9042 | 1.6854 | 2.1092 | 1.5993 | 2.0545 |
Hit Data
| Dataset | Hit |
|---|---|
| Protein Concentration | ✔ |
| Protein Localization | ✔ |
| Gene Expression | ✘ |
| Translational Efficiency | ✘ |
Endocytosis
| Temp | Actin Patch (Sac6-tdTomato) | Cortical Patch (Sla1-GFP) | Late Endosome (Snf7-GFP) | Vacuole (Vph1-GFP) |
|---|---|---|---|---|
| 37℃ | ||||
| RT |
Cell Cycle Omics
CYCLoPs (Rps30a-GFP)
| Gene / Allele | Actin Patch (Sac6-tdTomato) | Cortical Patch (Sla1-GFP) | Late Endosome (Snf7-GFP) | Vacuole (Sac6-tdTomato) |
|---|
| Gene | Images |
|---|
| Gene | Images |
|---|
Images are not yet available
Images are not yet available